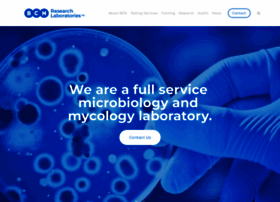

Door251.com
Visit door251.com-
1 day ago
Last scanned
-
5 years
Domain Age
-
No data
Daily Visitors
-
No data
Global Rank
Try our browser extension!
Try Website Informer Browser Extension
Door251.com
Visit door251.com
About Website
Updated:
永利澳门5396 zcom-首页
永利澳门5396 zcom【door251.com】的游戏特色、游戏亮点、以及游戏压分技巧的分享到这里就全部结束了,通过分享大家可以看到,这是一款十分靠谱的电玩游戏平台
Network Data
DNS used with this website include carter.ns.cloudflare.com, sara.ns.cloudflare.com.
-
1 day ago
Last scanned
-
5 years
Domain Age
-
No data
Daily Visitors
-
No data
Global Rank
Network
ADDRESSING DETAILS
-
DNS
carter.ns.cloudflare.com
sara.ns.cloudflare.com
Whois
OWNERSHIP
-
Created
2020-11-20
-
Expires
2021-11-20
-
Owner
REDACTED FOR PRIVACY
-
Registar
Domain International Services Limited
-
Owner Emails
admin@newvcorp.com
Domain & Keywords
The registrar of door251.com is Domain International Services Limited and the name expires on 2021-11-20. According to open source data, you can reach the owner at admin@newvcorp.com but please make sure you have a good reason for unsolicited messages. Their country of residence is Italy.
- soapstone sink
- capri sun giveawayy
- cute table for blogger post
- 澳门永利yl545
- 澳门永利注册送56yl
Websites similar to door251.com
-
 livesmartnaira.com
livesmartnaira.com-
Global rank
N/A
-
Daily Visitors
N/A
-
-
bcnlabs.com
bcnlabs.com-
Global rank
N/A
-
Daily Visitors
N/A
-
-
 ipietoon.com
ipietoon.com-
Global rank
N/A
-
Daily Visitors
N/A
-
-
 deliciousdesignstudio.com
deliciousdesignstudio.com-
Global rank
N/A
-
Daily Visitors
N/A
-
-
 cuteki.com
cuteki.com-
Global rank
N/A
-
Daily Visitors
N/A
-

